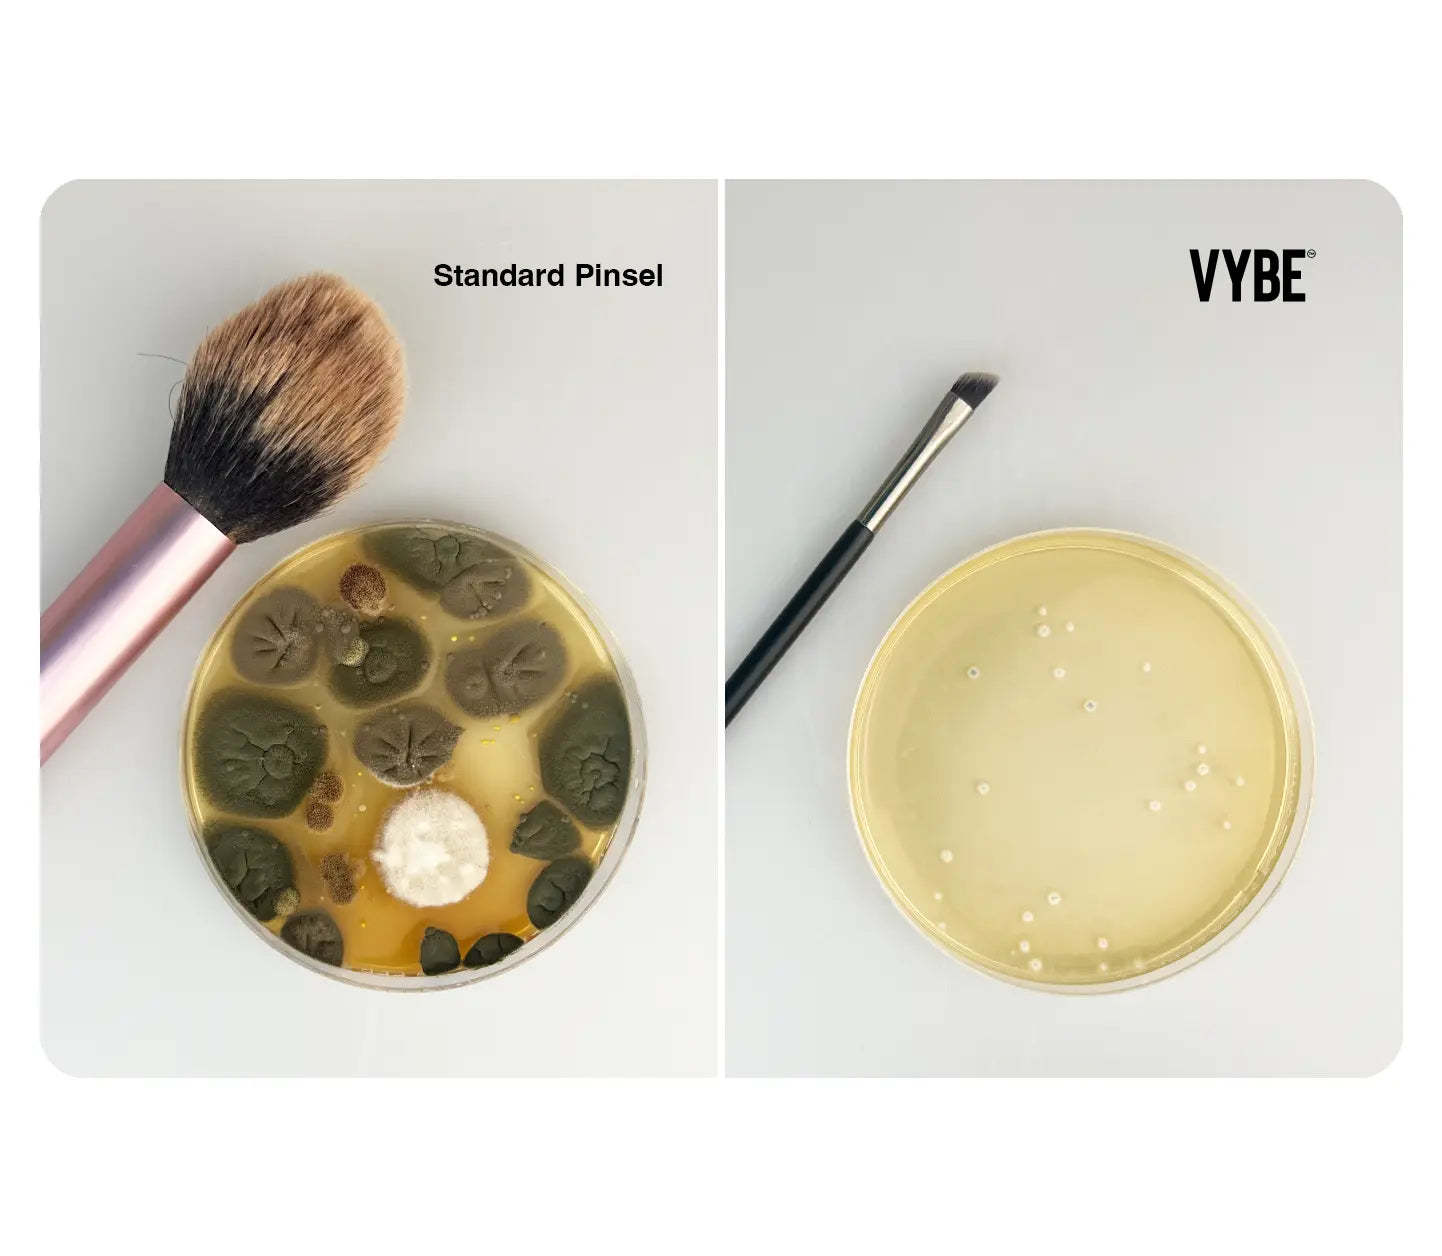

93,4% aller Pinsel sind voller Bakterien. Das schadet deiner Haut.
Auch wenn du deine Pinsel wäschst: durch Produktrückstände und Bakterien in Luftpartikeln bleiben sie trotzdem verkeimt.
Innovation aus Deutschland: Schütze deine Haut vor Unreinheiten mit den 1. antibakteriellen Makeup-Tools der Welt!
Silber-Ionen als 100% natürliches Mineral wehren Keime ab und schützen somit deine Haut vor Unreinheiten wie Akne, Rosacea und Hautflecken. Gleichzeitig altert deine Haut durch die geringere Keimbelastung deutlich langsamer. Unsere Formel ist 100% vegan, natürlich und sicher für deine Haut.
Die Silber-Ionen reagieren mit Schwefelverbindungen in bakteriellen Zellen und deaktivieren Enzyme, was zu einer Hemmung des Stoffwechsels und schließlich zum Absterben der Bakterien führt.
Hygienisch, präzise, sanft – Perfekte Pinsel für strahlende Haut.
-
Schützt deine Haut
-
Antibakterielle Technologie
-
Perfektes Finish
-
Langlebig und nachhaltig
Wer sagt, dass man ständig mehr Skincare-Produkte für reinere Haut benötigt?
Oft reicht es aus normale Makeup-Pinsel (die Ursache) aus der Routine zu entfernen.
Mit VYBE™ ist beginnt deine Skincare-Routine schon während dem Schminken. Bye-Bye, Bakterien. Hi, sexy Skin!
Präzise Linien mit dem VYBE™ Wing Liner Pinsel!
8 mal länger haltbar als herkömmliche Pinsel.
Damit sparst du nicht nur Geld, sondern tust auch der Umwelt etwas Gutes.

100 Tage Geld-Zurück-Garantie.
Wenn du nicht 100% zufrieden bist, erstatten wir dir den vollen Kaufpreis zurück.
Mehr als nur Makeup-Pinsel
Teste die VYBE™-Pinsel noch heute mit unserer 100 Tage Garantie risikofrei und erlebe den Unterschied. Deine Haut wird es dir danken!
















Gut für dich.
Und die Umwelt.
Fragen & Antworten
Was macht die VYBE™ Makeup-Pinsel so besonders?
Warum sind die VYBE™-Pinsel teurer?
Für welche Produkte kann ich die Pinsel verwenden?
Wie funktioniert die antibakterielle Technologie?
Sind die antibakteriellen Pinsel sicher für die Haut?
Wie oft sollte ich die VYBE™ Makeup-Pinsel reinigen?
Sind die VYBE™ Makeup-Pinsel auch für empfindliche Haut geeignet?
Wie lange halten die VYBE™ Makeup-Pinsel?
Sind die VYBE™ Makeup-Pinsel nachhaltig?
Sind die Pinsel für Anfänger geeignet?
Wie funktioniert die 100 Tage Garantie?